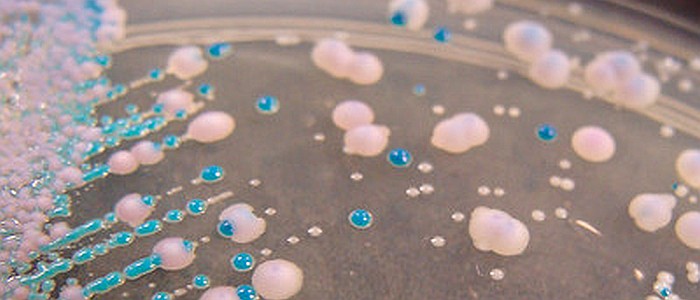
Глобальне потепління змушує смертоносні гриби вторгатися в наші тіла

Глобальне потепління змушує смертоносні гриби вторгатися в наші тіла
Хоча «Останні з нас» змушують нас турбуватися про зомбуючі офіокордицепси, реальність небезпечних грибкових інфекцій, швидше за все, буде більш приземленою, хоча потенційно такою ж смертельною.
Історично склалося так, що найкращою лінією захисту нашого організму від грибків було тепло тіла. Людські тіла приємні та теплі, при середній температурі 97,8 градуса за Фаренгейтом (36.5°C), яка зазвичай занадто висока для виживання інфекційних грибків.
Але, як повідомляє Wall Street Journal, підвищення температури через глобальне потепління може дати грибам нову еволюційну можливість адаптуватися до теплових стресів. І це може бути поганою новиною для нас, теплих тварин.
"Оскільки гриби постійно піддаються впливу підвищених температур, існує реальна ймовірність того, що деякі гриби, раніше нешкідливі, раптово стануть потенційними патогенами", – повідомив WSJ фахівець з інфекційних захворювань Пітер Паппас з Університету Алабами.
Зростання смертності від грибкових інфекцій вже викликає серйозні побоювання. За даними WSJ, 1970 року смертність від грибкових інфекцій у США обчислювалася сотнями. Але дані, надані Центрами контролю та профілактики захворювань (CDC), показують, що у 2018 році ця цифра зросла до більш ніж 4700 осіб. А зовсім недавно, у 2021 році, це число зросло до 7 200, хоча близько 1 900 з них були пов'язані з COVID-19, зазначає агентство, що, як і раніше, є чистим збільшенням.
Але це може бути лише початком, оскільки адаптація грибів до спеки – не єдиний наслідок підвищення температури. Згідно з дослідженням, опублікованим минулого місяця в журналі Proceedings of the National Academy of Sciences, це також може стимулювати прискорення еволюції деяких грибів.
У дослідженні дослідники зосередилися на криптококах, роді інвазивних грибів, відомих тим, що викликають смертельні захворювання та інфекції у людей з ослабленим імунітетом, які, за оцінками CDC, вже є причиною 112 000 смертей від інфекцій головного мозку у всьому світі на рік.
Під час вирощування в теплішому середовищі вони виявили, що у грибів швидкість руху "стрибаючих генів" — генів, які переміщуються між геномами та можуть викликати мутації — у п'ять разів вище, ніж зазвичай.
Асія Гуса, співавтор дослідження та мікробіолог з Університету Дьюка, розповіла WSJ, що ці зміни можуть бути причиною адаптації грибів до тепла.
В той самий час, згідно з недавнім аналізом, опублікованим у журналі Clinical Infectious Diseases, з 1950-х років у США поширилися інші смертоносні гриби, такі як Candida auris, histoplasma та coccidioides.
За даними аналізу, колись гістоплазма була поширена лише на Середньому Заході, але тепер повідомляється про неї у 94 відсотках штатів. І, за словами співавтора аналізу Андрія Спеца, експерта з грибкових інфекцій з Медичної школи Вашингтонського університету, долинна лихоманка, що викликається кокцидіоїдами й колись поширена лише на південному заході, тепер діагностується у «значній кількості» у більшості штатів. Компанія Spec також підтвердила, що це може спричинити підвищення температури.
"Ми продовжуємо говорити, що ці гриби рідкісні, але це має бути найпоширеніше рідкісне захворювання, тому що тепер вони всюди", – додав він.
Джерела: Wall Street Journal



